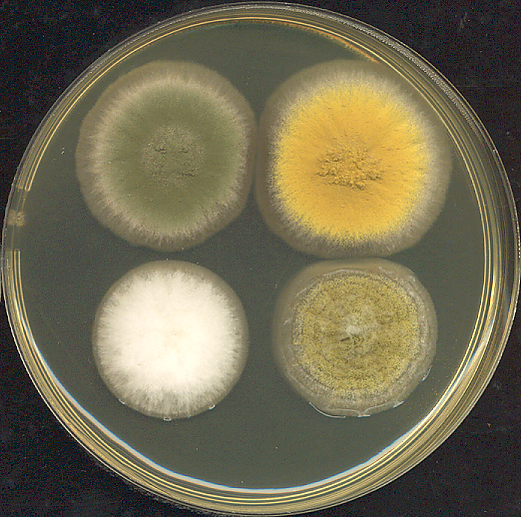

Аспергилл
Асперги́лл (лат. Aspergillus), — род высших аэробных плесневых грибов, включающий в себя несколько сотен видов, распространённых по всему миру в различных климатических условиях. Аспергиллы хорошо растут на различных субстратах, образуя плоские пушистые колонии, вначале белого цвета, а затем, в зависимости от вида, они принимают разную окраску, связанную с метаболитами гриба и спороношением. Мицелий гриба очень сильный, с характерными для высших грибов перегородками. Аспергиллы распространяются спорами, образующимися бесполым путём, что характерно для всего класса вообще. В то же время, Aspergillus fumigatus может[5] размножаться половым путём. «Аспергилл» впервые был каталогизирован в 1729 году итальянским священником и биологом Пьером Антонио Микели. Вид гриба под микроскопом напомнил Микели форму кропила для святой воды (Aspergillum, от лат. spargere — разбрызгивать), и он дал роду соответствующее название[6]. Сегодня название «аспергилл» также относят к бесполым спороформирующим структурам, схожим со всеми аспергиллами. Уже известно, что около одной трети всех видов имеют и половую фазу развития.
Общие сведения
Аспергилл | ||||||||||||||||
|---|---|---|---|---|---|---|---|---|---|---|---|---|---|---|---|---|
| Научная классификация | ||||||||||||||||
|
||||||||||||||||
| Латинское название | ||||||||||||||||
| Aspergillus P. Micheli ex Haller, 1768 | ||||||||||||||||
| Значимые виды | ||||||||||||||||
Несколько сотен видов[3], включая: |
Таксономия и классификация
Род Аспергилл (лат. Aspergillus) относится к царству Грибы, отделу Аскомикота (Ascomycota), классу Эуроциомицеты (Eurotiomycetes) и порядку Эуроциевые (Eurotiales)[7][8]. Согласно современной классификации, род входит в семейство Аспергилловые (Aspergillaceae). Ранее род Аспергилл, наряду с родом Penicillium, относили к семейству Трихокомовые (Trichocomaceae). Однако в результате ревизии, проведённой в 2011 году на основе молекулярных данных, это семейство было разделено, и Aspergillus был перенесён в новое семейство Aspergillaceae[9].
Типовым видом рода является Aspergillus glaucus.
Исторически аспергиллы относили к дейтеромицетам, или так называемым «несовершенным грибам» (Fungi imperfecti), поскольку у них была известна только бесполая стадия размножения (анаморфа), образующая конидии[10]. Дейтеромицеты являлись искусственной, сборной группой, куда включали все грибы с неустановленной половой стадией (телеоморфа)[11]. Со временем у многих видов Aspergillus была обнаружена телеоморфа, формирующая сумки (аски) с аскоспорами, что является ключевым признаком отдела аскомицетов. Это привело к возникновению дуальной номенклатуры, при которой один и тот же гриб мог иметь два научных названия: одно для анаморфы (например, Aspergillus) и другое для телеоморфы (например, Eurotium, Emericella)[12].
С развитием молекулярно-генетического анализа и официальным принятием в 2012 году принципа «Один гриб — одно название» эта система была упразднена. Филогенетические исследования подтвердили, что род Aspergillus является монофилетическим, и было решено сохранить за ним единое, наиболее известное название[13]. В результате виды, ранее известные как Eurotium, теперь классифицируются в секции Aspergillus рода Aspergillus. Термин «дейтеромицеты» утратил таксономический статус и используется лишь как неформальное описание[10].
Рост и распространение
Аспергиллы — высокоаэробные виды, и их можно обнаружить почти во всех богатых кислородом средах, где они обычно растут как плесень на поверхности субстрата. Как правило, грибы растут на богатых углеродом субстратах, таких как моносахариды (к примеру, глюкоза) и полисахариды (например, амилоза).
Виды аспергилл являются распространённым заражающим фактором крахмалистых продуктов (таких, как хлеб и картофель) и растут на поверхности многих растений и деревьев. Кроме того, некоторые виды выступают в роли эндофитов — микроорганизмов, живущих внутри тканей растений. Например, исследования показали, что эндофитный гриб Aspergillus cejpii, выделенный из корней риса, способствует росту растения[14], а штамм Aspergillus brasiliensis, обнаруженный в кратере вулкана, помогает растению-хозяину переносить тепловой стресс[15].
Представители рода обладают высокой устойчивостью к воздействиям внешней среды. Они способны расти в условиях высокой осмотической концентрации (например, в крепких растворах сахара или соли) и демонстрируют олиготрофность — способность к росту в обеднённых питательными веществами средах[16]. Примером этого является A. niger, который можно обнаружить на влажных стенах как компонент мильдью. В условиях дефицита питательных веществ аспергиллы могут вступать в синергетические взаимодействия с бактериями для выживания[17]. Исследования также показали, что штаммы A. niger из Антарктиды обладают повышенной устойчивостью к тяжёлым металлам и биоцидам, что связано с активной выработкой щавелевой кислоты[18].
Изменение климата оказывает существенное влияние на глобальное распространение аспергиллов. Согласно климатическим моделям, прогнозируется смещение ареалов патогенных видов на север. В частности, ареал Aspergillus fumigatus, основного возбудителя аспергиллёза, к 2100 году может расшириться на 77 %, создавая угрозу для здоровья миллионов людей в ранее холодных регионах Европы, Азии и Северной Америки[19][15], а ареал Aspergillus flavus, поражающего сельскохозяйственные культуры, может увеличиться на 16 %[20].
Ключевые виды
Род Аспергилл включает несколько сотен видов, некоторые из которых имеют особое значение в медицине, науке и промышленности[21]:
- Aspergillus fumigatus (Аспергилл дымящий) — наиболее частый возбудитель аспергиллёза, особенно инвазивных форм заболевания у людей с ослабленным иммунитетом[22].
- Aspergillus flavus (Аспергилл жёлтый) — известен как основной продуцент афлатоксинов, сильных канцерогенов, загрязняющих пищевые продукты (зерно, орехи). Также является одним из возбудителей аспергиллёза.
- Aspergillus niger (Аспергилл чёрный) — широко используется в биотехнологии для промышленного производства лимонной кислоты и различных ферментов[23]. Известен как «чёрная плесень» и может вызывать отомикоз (ушные инфекции)[24].
- Aspergillus oryzae (Аспергилл оризе) — играет ключевую роль в азиатской пищевой промышленности, где используется для ферментации при производстве саке, мисо и соевого соуса[25].
- Aspergillus terreus (Аспергилл терреус) — также является возбудителем инвазивного аспергиллёза у пациентов с иммунодефицитом[26].
- Aspergillus clavatus — известен как возбудитель аллергических заболеваний.
- Aspergillus nidulans — активно используется в научных исследованиях как модельный организм для изучения генетики эукариот. Может вызывать заболевания у человека[27].
Значение для человека
Виды аспергилл важны с медицинской и коммерческой точки зрения. Отдельные виды могут инфицировать человека и других животных. Некоторые инфекции, найденные на животных, изучались годами; в то время как другие виды, найденные на животных, описывались как новые и специфические для исследуемого заболевания. Иные были известны как уже использующиеся названия для организмов, таких как сапрофиты. Около 20 видов аспергилл являются медицинскими патогенами[28][29]. Существует целый ряд заболеваний человека, таких как инфекция наружного уха, поражения кожи и изъязвления, классифицируемые как мицетомы.
Другие виды важны в промышленности при изготовлении ферментативных препаратов. К примеру, спиртные напитки, такие как японская саке, предпочитают делать из риса или других крахмалистых ингредиентов (таких как маниока), вместо винограда или солодового ячменя. Типичные микроорганизмы, использующиеся для производства спирта, такие как дрожжевые грибки рода сахаромицеты, не могут ферментировать крахмал. Поэтому для расщепления крахмала на более простые сахара используется плесень кодзи (например, Aspergillus oryzae). Aspergillus oryzae, Aspergillus sojae, Aspergillus tamari используются для приготовления соевого соуса, а также различных видов соевой пасты — мисо, твенджана и других.
В Китае аспергиллы (Aspergillus acidus) используются при ферментации чая шу пуэр, а в Японии — кацуобуси, полуфабриката из тунца.
Грибы Aspergillus находят широкое применение для определения содержания неорганических катионов и анионов. Представители рода Аспергиллы также являются источниками натуральных веществ, которые могут быть использованы в производстве медикаментов для лечения различных заболеваний человека[30].
Возможно, самое обширное применение имеет Aspergillus niger, как основной источник лимонной кислоты. Этот организм обеспечивает подавляющую часть мирового производства лимонной кислоты, объём которого составляет почти 2,8 миллиона тонн в год[31]. A. niger также часто используется для получения истинных (нативных) и инородных ферментов, включая глюкозооксидазу и лизоцим белка куриных яиц. В 2024 году были одобрены новые ферменты, такие как целлюлаза из генетически модифицированного A. niger для пивоварения[32] и фруктозилтрансфераза из A. oryzae для производства пребиотиков[33]. Культуру редко выращивают на твёрдом субстрате (хотя в Японии эта практика ещё распространена), чаще её выращивают как глубинную культуру в биореакторе. При таком способе можно жёстко контролировать важные параметры и достичь максимальной продуктивности. Этот процесс также сильно облегчает отделение целевого химиката или фермента от питательной среды и, следовательно, намного более рентабелен.
В последние годы Aspergillus становится платформой для современных пищевых биотехнологий. Методом точной ферментации с использованием генетически модифицированных штаммов Aspergillus oryzae производят белки, идентичные животным, например, молочный белок бета-лактоглобулин[34]. Также разрабатываются съедобные мицелии с улучшенными питательными свойствами в качестве альтернативы мясу[35] и белки для создания альтернативных сыров[36].
Исследования
A. nidulans долгие годы использовался в качестве подопытного организма. Итальянский генетик и микробиолог Гвидо Понтекорво использовал гриб для демонстрации парасексуального процесса у грибов. A. nidulans стал в недавнем времени одним из первых организмов, чей геном был секвенирован исследователями Института Илай и Эдиты Л. Брэд. Начиная с 2008 года, был секвенирован геном ещё семи представителей рода аспергилл: использующиеся в промышленности A. niger (два штамма), A. oryzae и A. terreus, A. fischerianus (Neosartorya fischeri), A. flavus и A. fumigatus (два штамма). A. fischerianus почти никогда не бывает патогенным, однако имеет близкое родство с часто встречающимся патогеном A. fumigatus; он был частично секвенирован с целью лучшего понимания механизмов патогенности A. fumigatus.
Грибы рода Aspergillus являются богатым источником биологически активных вторичных метаболитов, многие из которых обладают фармацевтическим потенциалом. В середине 2025 года исследователи сообщили об открытии нового класса пептидных молекул — асперигимицинов, выделенных из гриба Aspergillus flavus[37]. Эти соединения продемонстрировали высокую эффективность против клеточных линий лейкемии, нарушая процесс митоза путём блокировки формирования микротрубочек[38]. Лабораторные исследования показали, что асперигимицины специфичны к злокачественным клеткам и не оказывают значительного влияния на здоровые, что делает их перспективными для создания таргетной терапии[37].
Исследования, особенно морских штаммов Aspergillus, продолжают выявлять новые биоактивные вещества. Так, за период с 2019 по 2024 год было выделено более 200 новых терпеноидов с антимикробной, противовирусной и противоопухолевой активностью[39]. Среди других открытий — афлаксантоны A и B, активные против Candida albicans и MRSA, а также меротерпеноиды, проявившие сильную антимикробную активность в отношении Staphylococcus aureus и Helicobacter pylori[40]. Кроме того, был выделен меротерпеноид аусталид X, показавший потенциальную активность против вируса SARS-CoV-2[41].
Возобновился интерес и к ранее известным метаболитам. Например, аспергилломаразмин А (AMA) активно изучается как ингибитор металло-β-лактамаз (MBLs) — ферментов, которые обеспечивают устойчивость бактерий к антибиотикам. AMA способен блокировать эти ферменты и восстанавливать чувствительность устойчивых бактерий к карбапенемам, что открывает перспективы для создания комбинированных препаратов для борьбы с супербактериями[42].
Из 250 видов аспергилл около 64 % не имеют известной половой стадии. Тем не менее, становится всё более ясно, что многие из этих видов, вероятно, имеют пока что неидентифицированную половую стадию. Половое размножение у грибков происходит двумя фундаментально различающимися способами. Это ауткроссинг (перекрёстное скрещивание) у гетероталломных грибков, в процессе которого две разные особи обмениваются ядрами, и самооплодотворение у гомоталломных грибков, где оба ядра происходят от одной и той же особи. В последние годы половые циклы были обнаружены у большого числа видов, ранее считавшихся бесполыми. Эти открытия отражают сосредоточенность современных эмпирических исследований на видах, имеющих конкретное отношение к человеку. Некоторые виды, для которых недавно подтверждено половое размножение, описаны ниже.
- A. fumigatus — вид аспергилл, наиболее часто поражающий людей в иммунодефицитных состояниях. В 2009 году было выявлено, что A. fumigatus имеет полнофункциональный гетероталломный половой цикл[43]. Для начала процесса размножения требуются изоляты штаммов с комплементарными типами спаривания.
- A. flavus — основной продуцент канцерогенного афлатоксина у зерновых культур по всему миру. Это также оппортунистический человеческий и животный патоген, вызывающий аспергиллёз у особей с ослабленным иммунитетом. В 2009 году у этого гетероталломного грибка была обнаружена половая стадия, возникающая при совместном развитии штаммов с противоположными половыми типами в подходящих условиях[44].
- A. lentulus — оппортунистический патоген человека, который вызывает инвазивный аспергиллёз с высоким уровнем смертности. Гетероталломная функциональная система размножения у A. lentulus была обнаружена в 2013 году[45].
- A. terreus широко используется в промышленности для производства важных органических кислот и ферментов, а также ранее служил основным источником для производства понижающего уровень холестерина препарата Ловастатин. В 2013 году было обнаружено, что A. terreus способен к половому воспроизведению, когда штаммы с противоположными половыми типами скрещивались в подходящих для культуры условиях[46].
Дальнейшие исследования, проведённые после 2014 года, подтвердили, что половая репродукция является не локальной особенностью, а глобальной характеристикой A. fumigatus. Анализ изолятов со всего мира в 2020 году показал, что 97% из них способны к половому размножению[47]. Более того, исследование 2023 года выявило, что этот вид обладает чрезвычайно высоким уровнем мейотической рекомбинации — большим, чем у любого другого известного организма. Это позволяет грибку полностью перестраивать свой геном за один цикл полового размножения, что может объяснять его способность быстро вырабатывать устойчивость к противогрибковым препаратам[48]. Поиск половых циклов продолжается и у других видов: геномный анализ штаммов A. niger выявил наличие у них генов типа спаривания, что указывает на потенциальную, но пока не обнаруженную в лаборатории способность к половому размножению[49].
Эти результаты исследований видов аспергилл согласуются с данными, накопленными при изучении других видов эукариот, и свидетельствуют о вероятном наличии полового поведения у общего предка всех эукариот[50][51][52]. A. nidulans — гомоталломный грибок, способный к самооплодотворению. Самооплодотворение затрагивает активацию тех же путей полового размножения, что и у видов, скрещивающихся ауткроссингом. Имеется в виду не то, что самооплодотворение проходит необходимые стадии, характерные для ауткроссинга, а то, что вместо этого требуется активация этих механизмов в пределах единственного представителя вида[53]. Подавляющее большинство видов аспергилл, демонстрирующих половые циклы, по природе гомоталломно (самооплодотворяющиеся)[54]. Такое наблюдение предполагает, что в целом виды аспергилл могут поддерживать половое размножение, даже несмотря на низкий уровень генетического разнообразия потомства как следствие гомоталломного самооплодотворения. A. fumigatus — гомоталломный (размножающийся ауткроссингом) грибок, который встречается в зонах, значительно различающихся климатом и условиями среды. Этот вид также демонстрирует низкую степень изменчивости и в пределах географических регионов, и в масштабах планеты[55], вновь наводя на мысль, что половое размножение — в данном случае размножение ауткроссингом — может сохраняться даже при низкой степени генетической изменчивости.
С начала 2010-х годов геномика грибов рода Aspergillus пережила революцию, связанную с развитием технологий секвенирования. Если до 2011 года были расшифрованы геномы лишь около десятка ключевых видов, то благодаря масштабным проектам это число выросло до более чем 250. Ключевую роль в этом сыграл проект Объединённого института генома (JGI) «Aspergillus whole-genus sequencing», инициированный в 2013 году с целью секвенировать геномы всех известных на тот момент видов рода.
Для хранения и анализа этого объёма данных были созданы и обновлены несколько ключевых онлайн-ресурсов:
- JGI MycoCosm — портал Объединённого института генома, который является одной из крупнейших баз данных по геномике грибов и содержит результаты проекта «Aspergillus whole-genus sequencing».
- FungiDB — база данных, входящая в ресурс VEuPathDB и специализирующаяся на патогенах эукариот. Она интегрирует геномные, транскриптомные и протеомные данные по множеству видов Aspergillus и особенно полезна для изучения механизмов вирулентности и лекарственной устойчивости[56][57].
- Aspergillus Genome Database (AspGD) — исторически центральный ресурс, предоставлявший высококачественную, курируемую вручную информацию по ключевым видам (A. nidulans, A. fumigatus, A. oryzae). В настоящее время данные AspGD интегрируются в FungiDB для создания единой, более мощной платформы для анализа[58][59][60].
Патогены
Некоторые виды аспергилл вызывают серьёзные заболевания у людей и животных, известные как аспергиллёз. Из нескольких сотен видов рода около 20 считаются медицинскими патогенами. Наибольшую клиническую значимость имеют:
- Aspergillus fumigatus — самый частый возбудитель инвазивного аспергиллёза, особенно у пациентов с ослабленным иммунитетом.
- Aspergillus flavus — второй по частоте возбудитель, известный как основной продуцент афлатоксинов — сильных гепатоканцерогенов, которые могут заражать пищевые продукты (орехи, зерно).
- Aspergillus niger — вызывает отомикоз (ушные инфекции) и реже — лёгочные заболевания.
- Aspergillus terreus — также является причиной инвазивного аспергиллёза у иммунокомпрометированных лиц.
- Aspergillus clavatus — известен как возбудитель различных аллергических заболеваний.
- Aspergillus nidulans — может вызывать заболевания у человека, хотя чаще используется как модельный организм в генетике.
В последние годы был выявлен гибридный вид Aspergillus latus, который также способен вызывать аспергиллёз, при этом он сложен для диагностики и обладает устойчивостью к некоторым противогрибковым препаратам[61][62].
Некоторые виды Aspergillus являются патогенами сельскохозяйственных культур. Они вызывают заболевания у многих зерновых, особенно у кукурузы, и могут синтезировать микотоксины (включая афлатоксин) непосредственно в урожае. В 2024 году был опубликован обзор, систематизирующий данные о видах Aspergillus, вызывающих болезни растений[63].
Аспергиллёз
Аспергиллёз — группа заболеваний, вызываемых грибами рода аспергилл. Наиболее распространённый подтип инфекций придаточных пазух носа, ассоциируемый с аспергиллёзом, вызывается видом A. fumigatus[64]. Симптомы включают жар, кашель, боль в груди или диспноэ (одышку), что также проявляется и в случае многих других заболеваний и поэтому может усложнить диагностику. Обычно восприимчивы только пациенты с уже ослабленной иммунной системой или страдающие от других болезненных лёгочных состояний. Главными формами заболевания у человека являются[65][66]:
- Аллергический бронхолёгочный аспергиллёз, поражающий больных с респираторными инфекциями, такими, как бронхиальная астма, муковисцидоз (кистозный фиброз), и синусит
- Острый инвазивный аспергиллёз — форма аспергиллёза, при которой грибки прорастают в окружающие ткани, более часто случается у людей с ослабленной иммунной системой, например на фоне СПИДа или обусловленной курсом химиотерапии
- Рассеянный инвазивный аспергиллёз — инфекция, широко распространившаяся в организме
- Аспергиллома — шаровидное грибковое образование, которое может сформироваться в пазухах и полостях, например, в лёгких
Чаще всего грибок проникает внутрь через дыхательные пути и рот и может поражать как дыхательную систему, так и центральную нервную систему, пищеварительный тракт, кожу, органы чувств и половую систему. Аспергиллёзный менингит или энцефалит в большинстве случаев заканчивается летальным исходом. Встречаются также грибковые поражения селезёнки, почек и костей аспергиллами, однако большей частью они вызваны вторичной инфекцией. Аспергиллёз дыхательных путей часто диагностируют у птиц, и известны определённые виды аспергилл, заражающие насекомых.
Ключевым фактором успешного лечения, особенно инвазивного аспергиллёза, является своевременная диагностика[67]. Современный подход включает комплексное использование нескольких методов:
- Визуализация: Компьютерная томография (КТ) остаётся основным методом для выявления характерных изменений в лёгких на ранней стадии.
- Лабораторные анализы: Широкое применение находит определение биомаркеров[68]. Основным маркером инвазивного аспергиллёза является галактоманнан, который определяется в сыворотке крови и, что более важно, в жидкости, полученной при бронхоальвеолярном лаваже (промывании бронхов)[69].
- Микробиологические исследования: Прямая микроскопия и посев материала, полученного из дыхательных путей, по-прежнему важны для подтверждения диагноза. В 2020 году были опубликованы международные критерии диагностики COVID-ассоциированного инвазивного лёгочного аспергиллёза (COVID-ИЛА), разработанные Европейской конфедерацией медицинской микологии (ECMM) и Международным обществом медицинской и ветеринарной микологии (ISHAM)[69], в которых рекомендуется исследовать материал, взятый при фибробронхоскопии[70].
Подходы к лечению аспергиллёза варьируются в зависимости от формы заболевания.
Эта наиболее опасная форма требует немедленной терапии. Согласно обновлённым клиническим рекомендациям, препаратами выбора являются азолы нового поколения: вориконазол, изавуконазол и позаконазол. Вориконазол часто используется в качестве стартовой терапии[68]. Для пациентов с высокой степенью риска может быть рекомендована комбинированная терапия вориконазола с препаратами из группы эхинокандинов (например, каспофунгин). В качестве альтернативных препаратов остаются липосомальная или липидная формы амфотерицина B[68].
Лечение этой формы направлено на улучшение состояния и предотвращение прогрессирования болезни. Рекомендуется длительный (часто пожизненный) приём пероральных противогрибковых препаратов из группы азолов. В случаях формирования аспергилломы может быть показано её хирургическое удаление, предпочтительно с использованием малоинвазивных методов. Для контроля кровохарканья могут применяться транексамовая кислота и эмболизация бронхиальных артерий. Важную роль играет мониторинг концентрации препаратов в крови для повышения эффективности и безопасности лечения[71].
См. также
- Микозы
- Микотоксин
- Оидиум
- Вспышка менингита 2012 г. в NECC
- Синдром больного здания[72]
- Список видов рода Аспергилл
Примечания
Литература
- Мир растений. В 7 т / Тахтаджян А. Л. (гл. ред.), под ред. Горленко М. В.. — М.: Просвещение, 1991. — Т. 2. Грибы. — С. 370—375. — ISBN 5—09—002841—9.
- Du C., Lin S.K., Koutinas A., Wang R., Dorado P., Webb C. A wheat biorefining strategy based on solid-state fermentation for fermentative production of succinic acid (англ.) // Bioresour Technol. : journal. — 2008. — November (vol. 99, no. 17). — P. 8310—8315. — doi:10.1016/j.biortech.2008.03.019. — PMID 18434138.
- Zirbes J.M., Milla CE. Steroid-sparing effect of omalizumab for allergic bronchopulmonary aspergillosis and cystic fibrosis (англ.) // Pediatr Pulmonol. : journal. — 2008. — June (vol. 43, no. 6). — P. 607—610. — doi:10.1002/ppul.20804. — PMID 18433040.
- Asan A. Aspergillus, Penicillium, and Related Species Reported from Turkey (англ.) // Mycotaxon : journal. — 2004. — Vol. 89, no. 1. — P. 155—157.
Ссылки
- Аспергиллус // Энциклопедический словарь Брокгауза и Ефрона : в 86 т. (82 т. и 4 доп.). — СПб., 1890—1907.
- Под редакцией А. Л. Тахтаджяна, главный редактор чл.-кор. АН СССР, проф. А. А. Федоров. Род Аспергилл (Aspergillus) // Жизнь растений: в 6-ти томах. — Просвещение.. — М., 1974.
- Aspergillus Comparative Database Comparative genomic resource at the Broad Institute
- Central Aspergillus Data Repository
- The Fungal Genetics Stock Center
- The Aspergillus/Aspergillosis Website An encyclopedia of Aspergillus for patients, doctors and scientists
- Aspergillus surveillance project at a large tertiary-care hospital. (PDF).
- The Aspergillus Genome Database